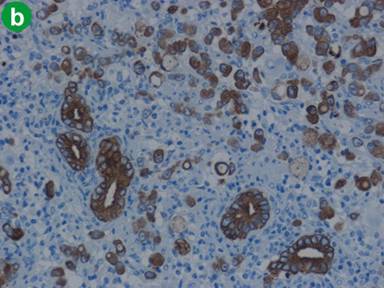

CASE REPORT
JOP. J Pancreas (Online) 2011 Mar 9; 12(2):162-166.
Signet-Ring Cell Carcinoma Co-Existing with Adenocarcinoma of the Ampulla of Vater. A Case Report
Hiroshi Maekawa, Mutsumi Sakurada, Hajime Orita, Koichi Sato
Department of Surgery, Shizuoka Hospital School of Medicine, Juntendo University. Shizuoka, Japan
ABSTRACT
Context We report a case of signet-ring cell carcinoma admixed with adenocarcinoma of the ampulla of Vater. Signet-ring cell carcinoma of the ampulla of Vater is rarely encountered in clinical practice. Case report A 78-year-old man was admitted to our hospital with jaundice. Computed tomography demonstrated dilatation of the biliary tract and an enhanced mass lesion measuring 1.5 cm in the pancreatic head. Endoscopic examination showed a reddish swollen papilla of Vater, and the pathological findings on a biopsy from the papilla suggested signet-ring cell carcinoma. A pancreaticoduodenectomy was performed with a diagnosis of carcinoma of the ampulla of Vater. Postoperative pathological examination showed that the tumor was composed of signet-ring cell carcinoma and tubular adenocarcinoma. The signet-ring cell carcinoma had infiltrated to the duodenal wall and pancreatic parenchyma. Both the signet-ring cell carcinoma and the adenocarcinoma were positive on immunohistochemical staining with 45M1. Conclusion Several cases of signet-ring cell carcinoma of the ampulla of Vater have previously been reported. In our case, the histological origin of both signet-ring cell and adenocarcinoma was hypothesized to have been pancreaticobiliary epithelial cells.
INTRODUCTION
Carcinoma of the ampulla of Vater represents about 5% of all carcinomas in the gastrointestinal tract [1]. Signet-ring cell carcinoma is more commonly found in the stomach while signet-ring cell carcinoma of the ampulla of Vater is rarely encountered clinically. We report a case of signet-ring cell carcinoma of the ampulla of Vater admixed with adenocarcinoma.
CASE REPORT
A 72-year-old man was admitted to our hospital with jaundice. He had a 15-year history of diabetes mellitus. There were no palpable masses or lymph nodes at physical examination. Full blood count and renal values were normal, but liver biochemistry showed total bilirubin of 11.7 mg/dL (reference range: 0.2-1.0 mg/dL), direct bilirubin of 8.8 mg/dL (reference range: 0.1-0.4 mg/dL), AST of 88 IU/L (reference range: 0-40 IU/L), ALT of 184 IU/L (reference range: 0-40 IU/L), alkaline phosphatase of 3,414 IU/L (reference range: 115-360 IU/L) and GGT of 1,356 IU/L (reference range: 10-60 IU/L). The serum level of CA 19-9 was elevated to 69 U/mL (reference range: 0-37 U/mL), that of DUPAN-2 was 1,320 U/mL (reference range: 0-150 U/mL) and that of SPAN-1 was 63 U/mL (reference range: 0-150 U/mL). Computed tomography showed dilatation of both the biliary tract and the main pancreatic ducts as well as an enhanced mass lesion measuring 1.5 cm in the pancreatic head (Figure 1). These findings suggested the existence of a tumor involving the ampulla of Vater. Endoscopic examination showed a reddish swollen papilla of Vater (Figure 2). Pathological findings on biopsy from the papilla suggested tubular adenocarcinoma and signet-ring cell carcinoma. Endoscopic examination of the stomach and the colon did not disclose any other foci of signet-ring cell carcinoma. Having diagnosed carcinoma of the ampulla of Vater, a pancreaticoduodenectomy was performed.


|
Figure 1. Abdominal axial computed tomography images. a. Computed tomography showed dilatation of the intrahepatic biliary tract. b. An enhanced mass lesion measuring 1.5 cm was detected in the pancreatic head. |

|
Figure 2. Endoscopic findings of the papilla of Vater. Endoscopic examination showed a reddish swollen papilla. |
Macroscopically, the tumor measured 1.5x1.5x2 cm and the tumor surface was exposed at the papilla, showing that its surface was nodular, but there was no ulceration. Histologically, signet-ring cell carcinoma was predominant, but partially well- to poorly-differentiated tubular adenocarcinoma also existed in the lesion (Figure 3a). Signet-ring cell carcinoma arose from the ampulla of Vater, slightly involving the muscularis propria of the duodenum and infiltrating the pancreatic parenchyma. The cytoplasm of the signet-ring cell carcinoma was positive for periodic acid Schiff staining (Figure 3b). Lymphatic and vascular involvement was seen in parts, but resected lymph nodes were free from metastasis. Immunohistochemical staining was performed and both the signet-ring cells and the adenocarcinoma cells were positive for human gastric mucin (45M1) (Figure 4). Both types of tumor cells were positive for CK7, MUC1 and MUC6, but negative for CK20, MUC2 and CD10 (Figure 5). The signet-ring cell carcinoma was partially positive for CDX2 (Figure 6). The carcinoma of the ampulla of Vater was diagnosed as T3N0M0 stage IIA according to the International Union Against Cancer TNM classification. The patient did not receive chemotherapy. Six months after surgery, the patient developed pneumonia. Subsequently, the pneumonia worsened and the diabetes mellitus also deteriorated. The patient finally died from multiple organ failure due to sepsis. However, no recurrence of the signet-ring cell carcinoma was detected on repeated imaging studies.


|
Figure 3. Histopathological findings of the carcinoma. a. Signet-ring cell carcinoma co-existing with tubular adenocarcinoma (H&E x50). b. The signet-ring cell carcinoma was positive for periodic acid Schiff staining (H&E x50). |

|
Figure 4. Immunohistochemical findings for human gastric mucin (45M1). Signet-ring cells and adenocarcinoma cells were both positively stained. (original magnification x100). |

|
Figure 5. Both signet-ring cells and adenocarcinoma cells stained positively for CK7, but negatively for CD20 (a. H&E, x100; b. Immunohistochemical findings for CK7, x100; c. CK20, x100). |

|
Figure 6. Immunohistochemical findings for CDX2. Signet-ring cells were partially positive for CDX2 (x100). |
DISCUSSION
Signet-ring cell carcinoma was first described by Sekoguchi et al. in 1979 [2]. Since then there have been 23 cases previously reported [2, 3, 4, 5, 6, 7, 8, 9, 10, 11, 12, 13, 14, 15, 16, 17, 18, 19, 20]. Histologically, the origin of signet-ring cells remains unknown, but the following hypotheses have been proposed by various investigators. One is that signet-ring cell carcinoma arises from ectopic gastric mucosa found in the duodenum. Gardner et al. and Ramia et al. observed ectopic gastric mucosa peritumorally [3, 10]. Another theory is that signet-ring cell carcinoma arises from areas of gastric-type metaplastic epithelia. These metaplastic changes are considered to be a protective response to elevated acidity and have usually been seen at the duodenal bulb in peptic ulcer patients [21]. In this theory, signet-ring cell carcinoma originates from periampullary duodenal heterotopias of an ulcerative etiology and expands to the ampulla of Vater. In our case, there was no ectopic gastric mucosa found in the peritumoral mucosa, and the patient had no history of peptic ulcer disease.
The histopathological findings of three previously reported cases of signet-ring cell carcinoma of the ampulla of Vater showed that signet-ring cell carcinoma co-existed with adenocarcinoma, as in our case (Table 1). We hypothesized that the signet-ring cell carcinoma in our case might have differentiated from common adenocarcinoma, which means that signet-ring cell differentiation from the common type of adenocarcinoma could be another theory explaining the histogenesis of signet-ring cell carcinoma. However, this hypothesis fails to explain why most previously reported cases of signet-ring cell carcinoma of the ampulla of Vater did not demonstrate coexisting adenocarcinoma. A tumor microdissection technique should have been used but this technique was not available in our hospital. So this hypothesis could not be proven.
|
Table1. Reported cases of signet ring cell carcinoma of the ampulla of Vater. |
|
|
Case |
Histopathology |
|
Sekoguchi et al., 1979 [2] |
Co-existence of SRCC and ADSC |
|
Gardner et al., 1990 [3] |
Pure SRCC |
|
Arnal Monreal et al., 1994 [4] |
Co-existence of SRCC and endocrine cells |
|
Casella et al., 1994 [5] |
Pure SRCC |
|
Tseng et al., 2002 [6] |
Pure SRCC |
|
Hara et al., 2002 [7] |
Pure SRCC |
|
Nabeshima et al., 2003 [8] |
Pure SRCC |
|
Eriguchi et al., 2003 [9] |
Pure SRCC |
|
Ramia et al., 2004 [10] |
Pure SRCC |
|
Fang et al., 2004[11] |
Pure SRCC |
|
Li et al., 2004 [12] |
Co-existence of SRCC and ADC |
|
Zhou et al., 2004 [13] |
Four cases reported but unknown in detail |
|
Prohit et al., 2005 [14] |
Pure SRCC (biopsy specimen) |
|
Valeri et al., 2005 [15] |
Pure SRCC |
|
Bloomston et al., 2006 [16] |
Pure SRCC |
|
Akatsu et al., 2007 [17] |
Pure SRCC |
|
Gao et al., 2009 [18] |
Pure SRCC |
|
Ishibashi et al., 2009 [19] |
Pure SRCC |
|
Tas et al., 2011 [20] |
Pure SRCC (bioptic specimen) |
|
Present study |
Co-existence of SRCC and ADC |
|
ADC: adenocarcinoma; ADSC: adenosquamous cell carcinoma; SRCC: signet ring cell carcinoma |
|
Kimura et al. histologically subdivided carcinoma of the ampulla of Vater into the intestinal-type and pancreaticobiliary-type [22]. Fischer and Zhou demonstrated differences between these groups on staining for immunohistochemical markers. The intestinal type expressed the immunohistochemical marker profile of intestinal mucosa, that is, negative for CK 7 and positive for CK 20 and MUK2. However, the pancreaticobiliary type shows the immunohistochemical profiles of pancreaticobiliary mucosa, that is, positive for CK 7 and negative for CK 20 and MUC 2 [23]. Fischer and Zhou described the immunohistochemical profiles of three signet-ring cell carcinomas of the ampulla of Vater as follows: all the specimens of signet-ring cell carcinoma were negative for CK 7 and positive for CK 20 and MUC 2 [23]. In our case, the tumor cells were positive for CK7 and negative for CK20 and MUC 2. We suspected that there may be several patterns of immunohistochemical staining for apomucin in signet-ring cell carcinoma of the ampulla of Vater. Our case was thought to be similar to the pancreaticobiliary type because of the positive findings for CK7 and the negative finding for MUC2 staining. But we think it is difficult to conclude that our case was a real pancreaticobiliary type using only these immunohistochemical findings. The positive finding for human gastric mucin (45M1) staining also suggested that both the signet-ring cell carcinoma and the adenocarcinoma in our case were similar to the pancreaticobiliary type. Sonoue et al. suggested that the pancreatobiliary mucosa of the ampulla of Vater demonstrates regenerative hyperplasia in response to some stimuli, representing a functional modification and expressing some features of a gastric surface marker for immunohistochemical staining [24].
In conclusion, we encountered a case of signet-ring cell carcinoma of the ampulla of Vater. Our case was thought be a pancreaticobiliary type from the results of the immunohistochemical staining. However, the histogenesis of signet-ring cell carcinoma remains unknown and additional investigation is required to confirm its histological origin.
Received December 7th, 2010 - Accepted January 13th, 2011
Key words Ampulla of Vater; Carcinoma, Signet Ring Cell
Conflicts of interest The authors have no potential conflicts of interest
Correspondence
Hiroshi
Maekawa
1129 Nagaoka
Izu-no-kuni city, Shizuoka
Japan
Phone: +81-55.948.3111
Fax: +81-55.946.0514
E-mail: hmaekawa0201@gmail.com
References
1. Baczako K, Büchler M, Beger HG, Kirkpatrick CJ, Haferkamp O. Morphogenesis and possible precursor lesions of invasive carcinoma of the papilla of Vater: epithelial dysplasia and adenoma. Hum Pathol 1985; 16:305-10. [PMID 3972407]
2. Sekoguchi T, Mizumoto R. Clinicopathological study of papilla of Vater. Geka Chiryo 1979; 41:1-5.
3. Gardner HA, Matthews J, Ciano PS. A signet-ring cell carcinoma of the ampulla of Vater. Arch Pathol Lab Med 1990; 114:1071-2. [PMID 2171451]
4. Arnal Monreal FM, Lorenzo Patiño MJ, Sacristán F, Ghanimé Saide G. Signet ring cell carcinoma of the Vater's ampulla. Rev Esp Enferm Dig 1994; 85:391-3. [PMID 8049111]
5. Casella R, Rittmann WW, Meier R, Wegmann W, Widmer MK, Hunger T. Signet ring cell carcinoma of Vater`s papilla: a very rare malignancy. Helv Chir Acta 1994; 60:987-90. [PMID 7876027]
6. Tseng LJ, Jao YT, Mo LR. Signet ring cell carcinoma of major papilla. Gastrointest Endosc 2002; 56:733. [PMID 12397285]
7. Hara T, Kawashima H, Ishigooka M, Kashiyama M, Takanashi S, Hosokawa Y. Signet-ring cell carcinoma of the ampulla of Vater: A case report. Hepatogastroenterology 2002; 49:561-3. [PMID 11995497]
8. Nabeshima S, Kishihara Y, Nabeshima A, Yamaga S, Kinjo M, Kashiwagi S, Hayashi J. Poorly differentiated adenocarcinoma with signet-ring cells of the Vater's ampulla, without jaundice but with disseminated carcinomatosis. Fukuoka Igaku Zasshi 2003; 94:235-40. [PMID 14509231]
9. Eriguchi N, Aoyagi S, Jimi A. Signet-ring cell carcinoma of the ampulla of Vater: report of a case. Surg Today 2003; 33:467-9. [PMID 12768376]
10. Ramia JM, Mansilla A, Villar J, Muffak K, Garrote D, Ferron JA. Signet ring cell carcinoma of the Vater`s ampulla. JOP. J Pancreas (Online) 2004; 5:495-7. [PMID 15536289]
11. Fang CL, Chu JS, Hsieh MC, Wu MS. Signet-ring cell carcinoma of the ampulla of Vater. J Formos Med Assoc 2004; 103:793-6. [PMID 15490032]
12. Li L, Chen QH, Sullivan JD, Breuer FU. Case report: Signet-ring cell carcinoma of the ampulla of Vater. Ann Clin Lab Sci 2004; 34:471-5. [PMID 15648791]
13. Zhou H, Schaefer N, Wolff M, Fischer HP. Carcinoma of the ampulla of Vater: comparative histologic/immunohistochemical classification and follow-up. Am J Surg Pathol 2004; 28:875-82. [PMID 15223956]
14. Purohit RC, Kant K, Bhargava N, Kothari N, Purohit V. Signet ring cell carcinoma of the ampulla of Vater in a young adult. Indian J Gastroenterol 2005; 24:222-3. [PMID 16361773]
15. Valeri S, Caricato M, Ripetti V, Crucitti P, Ausania F, Garberini A, et al. Signet-ring cell carcinoma of the Vater`s ampulla: report of a clinical case. Suppl Tumori 2005; 4:S61. [PMID 16437905]
16. Bloomston M, Walker M, Frankel WL. Radical resection in signet ring carcinoma of the ampulla of Vater: Report of an 11-year survivor. Am Surg 2006; 72:193-5. [PMID 16536256]
17. Akatsu T, Aiura K, Takahashi S, Kameyama K, Kitajima M, Kitagawa Y. Signet-ring cell carcinoma of the ampulla of Vater: report of a case. Surg Today 2007; 37:1110-4. [PMID 18030577]
18. Gao JM, Tang SS, Fu W, Fan R. Signet-ring cell carcinoma of ampulla of Vater: contrast-enhanced ultrasound findings. World J Gastroenterol 2009; 15:888-91. [PMID 19230055]
19. Ishibashi Y, Ito Y, Omori K, Wakabayashi K. Signet ring cell carcinoma of the ampulla of Vater. A case report. JOP. J Pancreas (Online) 2009; 10:690-3. [PMID 19890196]
20. Tas A, Ozer E, Koklu S, Kocak E. Signet ring cell carcinoma of the ampulla of Vater :a rare cause of acute pancreatitis. Scand J Gastroenterol 2011; 46:126-7. [PMID 20950208]
21. Hoedemaeker PJ. Heterotopic gastric mucosa in the duodenum. Digestion 1970; 3:165-73. [PMID 4915587]
22. Kimura W, Futakawa N, Zhao B. Neoplastic diseases of the papilla of Vater. J Hepatobiliary Pancreat Surg 2004; 11:223-31. [PMID 15368105]
23. Fischer HP, Zhou H. Pathogenesis of carcinoma of the papilla of Vater. J Hepatobiliary Pancreat Surg 2004; 11:301-9. [PMID 15549428]
24. Sonoue H, Suda K, Nobukawa B, Abe H, Arakawa A, Hirai S, Matsumoto T. Does ampullary carcinoma arise from distended glands in the papilla of Vater? J Hepatobiliary Pancreat Surg 2008; 15:161-8. [PMID 18392709]